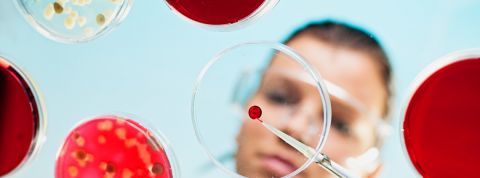
Civilisation in vitro : « On crée des bio-objets sans les maîtriser, à la manière de Frankenstein » Une chercheuse manipule de la matière dans une boîte de pétri

Gamètes, cellules souches, ovocytes… On fabrique des objets vivants par millions comme l’on produit des objets inertes, de manière standardisée et industrielle. Le tout sans réelle prise de recul. C’est ce que décrit la sociologue Céline Lafontaine dans Bio-objets, les nouvelles frontières du vivant, paru aux éditions du Seuil en mars 2021.
Des ovocytes congelés, de la peau artificielle imprimée en 3D, des cellules souches animales ou humaines… Une myriade de « bio-objets », ces objets hybrides mi-vivants mi-artificiels cultivés dans les laboratoires, peuplent notre monde. Ils sont utilisés en médecine, en agriculture, mais aussi dans l’industrie pharmaceutique et cosmétique. Ils sont produits de manière industrielle, dans une logique productiviste, et sont souvent porteurs de grand espoir : donner la vie, réparer, régénérer, soigner l’incurable. Pour la chercheuse Céline Lafontaine, ils méritent une attention particulière car ils changent fondamentalement notre rapport au vivant. Ils « procurent la dangereuse illusion de maîtriser la vie, de pouvoir la créer et la refaçonner à volonté », écrit-elle dans Bio-objets, les nouvelles frontières du vivant (Seuil, 2021).
Cette professeure de sociologie à l’Université de Montréal étudie depuis plus de quinze ans les problématiques liées au vivant et aux technosciences. Avant ce dernier ouvrage, elle publiait au Seuil La société postmortelle. L'individu, la mort et le lien social à l’ère des technosciences (2008), et Le Corps-Marché. La marchandisation de la vie humaine à l’ère de la bioéconomie (2014). Dans Bio-objets, elle livre une enquête fouillée et fascinante sur les caractéristiques de ces bio-objets, qui prolifèrent en silence. Son analyse est nuancée, mais critique sur le peu de questionnements suscités par ces nouvelles formes de vie.
Dans votre livre vous parlez d’une « civilisation in vitro ». Pourquoi les technologies in vitro sont une caractéristique clé de notre civilisation ?
Céline Lafontaine : Les premières images que l’on a de notre époque sont souvent numériques. On a beaucoup parlé de la société de communication, d’information, à travers internet et le cyberespace notamment. Mais si on s’intéresse à notre rapport concret au vivant, à nous-mêmes et au monde, ce sont surtout les bio-objets qui le définissent. Je parle de civilisation in vitro d’abord parce que des millions d’êtres humains sont nés de fécondation in vitro. Toute l’agriculture industrielle, donc tout ce qu’on mange relève des technologies in vitro. Une grande partie de la médecine, de la recherche biomédicale aussi. Les bio-objets sont à la fois invisibles – il n’y a pas grand-chose à voir dans une boîte de Petri – et partout. Il faut s’y intéresser car ils inversent toutes les catégories de notre société occidentale : vivant et non-vivant, sujet et objet. Ils déconstruisent la vie organique, en permettant de transformer et manipuler le vivant.
Vous décrivez une accélération du nombre de bio-objets, et ce dans tous les secteurs, et même une industrialisation de leur production. Comment expliquer jusqu'ici l’absence de débat philosophique et sociologique à l’égard de ces objets ?
C.L. : Ils sont invisibilisés. Ce sont des objets qui sont élaborés dans les laboratoires, des cliniques, des hôpitaux, donc ils ne sont pas accessibles facilement. Ils forment notre trame de vie quotidienne, mais ce ne sont pas des objets du quotidien. Ils demeurent cachés. Même s'ils sont devenus des icônes. Quand on pense aux sciences de la vie, la première image qui vient souvent est une boîte de Petri, une cellule in vitro. Ils font donc partie de notre imaginaire mais nous n’y avons pas accès facilement, contrairement au numérique.
L’autre raison de cette invisibilisation, beaucoup plus fondamentale, c’est que les bio-objets font partie d’une économie de la promesse. Ces objets sont porteurs d’espoir, de grand espoir. La possibilité de porter un enfant grâce à la fécondation in vitro, par exemple, représente un très grand espoir. Ils sont liés à plein d’affects, ce qui explique qu’on ne les voit jamais pour ce qu’ils sont : des objets technoscientifiques, mi-vivants mi-objets. On ne les voit que par le filtre des espoirs qu’ils suscitent. On questionne chaque application et son cadre éthique, mais il y a peu d’approches transversales, ce qui participe à camoufler les dimensions matérielles des bio-objets. Cette absence de perspective ne permet pas de questionner leur mode de production industrielle, et leur prolifération.
L’économie de la promesse à laquelle vous faites référence existe dans d’autres domaines technologiques comme l’intelligence artificielle, dont on survend beaucoup les capacités. En quoi est-elle si caractéristique des bio-objets ?
C.L. : L’économie de la promesse est un terme large qui définit les politiques d’innovation en sciences. Pour obtenir des capitaux, les chercheurs font des promesses sur les retombées éventuelles de recherches qu’ils n’ont pas encore réalisées. Et la plupart des chercheurs sont d’ailleurs mal à l’aise avec cela. On retrouve cette logique dans les nanotechnologies et dans l’intelligence artificielle, effectivement. Les biotechnologies s’inscrivent aussi dans cette économie de la promesse, mais la promesse prend une dimension bien plus fondamentale dans leur cas car on touche à la vie, à la mort… Cette économie de la promesse se transforme en économie de l’espoir et même en économie de l’affect. La dimension économique est alors moins visible. Lorsque j’ai passé un mois dans la start-up de bio impression Poïetis à Pessac près de Bordeaux (qui imprime en 3D des peaux artificielles pour les laboratoires pharmaceutiques, ndlr), j’ai pu constater que des personnes appelaient en demandant s’ils pouvaient bénéficier de la technologie de Poïetis pour un proche grand brûlé, par exemple… Des applications très éloignées de ce que faisait réellement Poïetis.
C’est une promesse parfois inatteignable, car vous montrez que l’efficacité de ces bio-objets est loin d’être prouvée…
C.L. : Dans d’autres domaines médicaux, on sait que le vivant est une matière extrêmement complexe et qu’on ne peut pas le maîtriser. N’importe quel médecin dira par exemple que la chimiothérapie ne fonctionne que sur une partie de ses patients. Et la pandémie est une nouvelle preuve qu’on ne maîtrise pas le vivant. Or, dans le domaine des biotechnologies, on présente souvent les bio-objets – dans les médias et même les articles scientifiques – comme des miracles, et surtout comme des matières qu’on est capable de maîtriser. Cela ne correspond pas à la réalité.
La fécondation in vitro est pratiquée depuis 40 ans de manière commerciale et industrielle, et il n’y a pourtant que 40 % de réussite pour un premier essai. Il y a pourtant une adhésion très forte de la part des citoyens, une croyance en la fécondation in vitro. Tous les États ont légiféré sur cette question, comme si c’était quelque chose qui fonctionnait effectivement. Alors que la somme des échecs et des problèmes sociaux engendrés est beaucoup plus grande que le nombre d’enfants nés d’une FIV.
En quoi la prolifération des bio-objets peut-elle être problématique ?
C.L. : On crée des bio-objets sans les maîtriser. C’est la méthode de Frankenstein. On a aucune idée des effets globaux dynamiques de ces objets dans l’environnement. Cette prolifération perpétue l’idée que le corps, le vivant en général, est une machine malléable. Or, c’est fondamentalement faux. Les chercheurs que j’ai rencontrés au sein de Poïetis sont d’ailleurs très conscients qu’ils manipulent une matière très complexe.
Ces technologies sont par ailleurs le signe d’une objectivation des corps, qui touche avant tout le corps des femmes, comme vous le précisez.
C.L. : Oui et cela a d’ailleurs toujours été le cas dans l’histoire de la biologie. On peut faire le parallèle avec l’agriculture et l’élevage, où ce sont surtout les femelles qui sont exploitées : les vaches laitières, les poules pondeuses, les truies reproductrices… Le corps féminin est davantage mobilisé. La congélation d’ovocytes est un bon exemple d’objectivation du corps des femmes. Il concerne de plus en plus de femmes, y compris en bonne santé et jeunes. Il y a une très forte augmentation des jeunes femmes qui ont recours à cette pratique en Europe et aux États-Unis. Cette industrie, qui a été notamment popularisée par Sheryl Sandberg (directrice des opérations de Facebook, ndlr), promet aux femmes d’ « investir dans leur fertilité », de se préparer à l’éventualité de problèmes d’infertilité, de construire une carrière avant d’avoir des enfants. C’est un rapport au corps très néolibéral, une représentation du corps comme capital.
Vous opposez la lutte contre le réchauffement climatique et la prolifération de ces bio-objets, en quoi ces deux tendances sont-elles incompatibles ?
C.L. : Cela me paraît incohérent de lutter contre les émissions de gaz à effets de serre d’un côté, et d’être pour la fécondation in vitro et la congélation d’ovocytes de l’autre. Car les bio-objets obéissent à la même logique productiviste que l’on dénonce lorsqu’on s'attaque au réchauffement climatique. Mon but n’est pas de prendre parti pour ou contre les bio-objets, mais plutôt d’essayer de faire voir un phénomène qui n’est pas visible et d’amorcer une réflexion.




Participer à la conversation